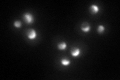
YLR221C
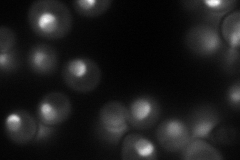
YLR221C
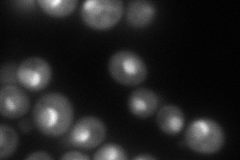
YLR221C
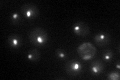
YLR221C

View description
Protein with a likely role in ribosomal maturation, required for accumulation of wild-type levels of large (60S) ribosomal subunits; binds to the helicase Dbp6p in pre-60S ribosomal particles in the nucleolus
Localization:
Intensity:
Fold change:
Significance:
-
C’ GFP library in SD
nucleolus75.83 -
N' NOP1pr-GFP in SD
nucleolus102.299 -
N' TEF2pr-mCherry in SD
nucleus,nucleolus133.801 -
N' NATIVEpr-GFP in SD

nucleus,nucleolus66.7798 -
N' TEF2pr-VC and Cyto-VN in SD

nucleus,nucleolus54.2266 -
C’ GFP library in SD+DTT

nucleolus48.80.64No -
C’ GFP library in SD+H2O2

nucleolus47.490.62Yes -
C’ GFP library in Starvation Media
nucleolus47.970.63Yes -
C’ GFP library on the background of Pup2-DaMP

nucleolus -
C’ GFP library on the background of CCT mutant

nucleolus62.50060.824175No
